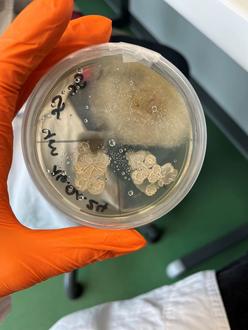

Johannes-Kepler-Gymnasium Lebach: MINT-EC-Tag „Bakterien - Großes entsteht im Kleinen" - Schülerartikel
Am 18.04.24 durften wir am Workshop „Bakterien - Großes entsteht im Kleinen“ am INNOZ SchülerZukunftsZentrum in Merzig-Wadern teilnehmen. Dabei stand vor allem das praktische Lernen im Labor im Vordergrund. Über den Tag verteilt standen Experimente mit Leuchtbakterien, Antibiotika sowie mit unterschiedlichsten Infektionen wie zum Beispiel der Schmierinfektion auf dem Programm. Zudem wurde getestet, was das Händewaschen bzw. das Desinfizieren der Hände wirklich bringen und inwiefern Bakterien davon abgetötet werden können. Wir durften nicht nur selbst Nährböden herstellen, sondern auch bereits angelegte Bakterienkolonien auswerten. Die eingeschobenen Theorieblöcke behandelten zum Beispiel den Aufbau oder die Vermehrung eines Bakteriums sowie die Wirkung eines Antibiotikums. Alles in allem lässt sich sagen, dass der Tag sehr informativ war und uns neue Einblicke in die Welt der Bakterien bieten konnte.
(Marie Bohlander, 9c)